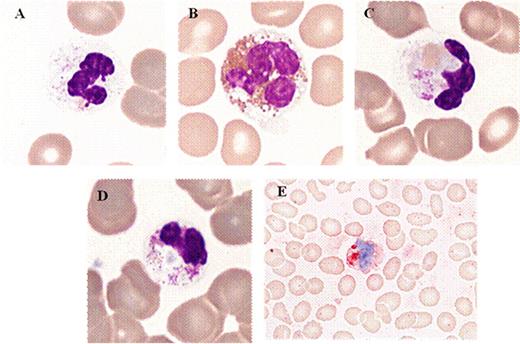
Figure 1:. Typical morphological features in patients with ider(20q) (peripheral blood).

Abstract
Abstract 2942
In 2004, a variant of del(20q) was described in MDS, i.e. an isochromosome of the long arm of chromosome 20 with interstitial loss of material [ider(20q)]. At the present time, 40 cases of ider(20q) have been reported in hematological malignancies, i.e. twenty-nine in MDS. The reported frequency of ider(20q) compared to del(20q) in MDS and AML, is 0.49% versus 2.49% and 0.26% versus 2.63%, respectively. No specific morphological anomaly was reported for MDS with del(20q) or ider(20q). Del(20q) preferentially involved the erythroid and megakaryocytic precursors and was associated with elliptocytosis. The prognostic significance of del(20q) is generally considered as good with some controversy. Until now, the prognostic significance of ider(20q) remains debated.
The discovery of highly dysplastic neutrophils with neutrophil erythrophagocytosis in a patient with MDS and ider(20q) prompted us to analyze and compare the morphology of blood (PB) and bone marrow (BM) cells in MDS patients with del(20q) or ider(20q). The second aim was to compare clinical features of patients with MDS associated with del(20q) and ider(20q).
34 patients with MDS displaying del(20q) and/or ider(20q) were included in this retrospective multicentric study. May-Grunwald-Giemsa stained PB and BM smears were analyzed for dysplasia in the erythroid, myeloid and megakaryocytic lineages. All cases were revised independently by at least 2 cytologists from 2 or 3 centers. Cytogenetic analysis was performed at diagnosis on short term BM cultures using conventional techniques, and karyotypes were described according to the International System for Human Cytogenetic Nomenclature (ISCN 2009). When possible (n=20), metaphase and interphase FISH studies were performed on the same suspension as used for conventional cytogenetic analysis to confirm the presence of ider(20q) when cytogenetically suspected, to look for subclones with del(20q), and to establish the percentage of nuclei with ider(20q) and del(20q). All patients were followed from the date of clinical diagnosis to transformation in acute leukemia or death. The presence of autoimmune manifestations and the International Prognostic Scoring System (IPSS) were also registered.
For the first time, morphological abnormalities on PB and BM were found sensitive and specific for this recently described cytogenetic entity. Indeed, hypogranulated and vacuolized neutrophils and neutrophil erythrophagocytosis (Figure 1) were present on PB and BM in MDS with ider(20q), with a sensitivity ranging from 65% to 75%. Moreover, the sensitivity and specificity of a morphological score based on the assessment of 9 morphological criteria reached 70% and 90.5%, respectively, in MDS patients with isolated ider(20q). This score included hypogranular and vacuolized neutrophils (in association with non dysplastic neutrophils), hypogranular and vacuolized eosinophils (with sometimes difficult differentiation between neutrophils and eosinophils), neutrophil erythrophagocytosis, elliptocytosis and thrombocytophagocytosis on PB. Hypogranular and vacuolized neutrophils and eosinophils, erythrophagocytosis by neutrophils and deeply lobulated and hyperlobulated megakaryocytes (stag-horn-like) were observed in BM. In the present study, the outcome of patients with del(20q) and with ider(20q) was not statistically different. Indeed, the number of progressions and deaths was slightly higher in the ider(20q) group. However, the frequency of autoimmune manifestations (AIMs) in del(20q) and ider(20q) group were 9.5% (2/21) and 8% (1/13), respectively (p>0.05). The mean IPSS was 0.5 in both groups. The OS (p=0.3744) and PFS (p=0.2497) did not differ statistically in MDS with del(20q) and ider(20q). All deaths were related to the MDS except for one patient with ider(20q) whose dead was from unknown origin. The median OS and PFS were 68 and 65 months, respectively, in the ider(20q) group whereas they were not reached in the del(20q) group.
We proposed a morphological score based mainly on hypogranulated and vacuolized neutrophils and neutrophil erythrophagocytosis on PB and BM which can be used to predict ider(20q) in MDS patients. The prognosis seems not to differ between MDS with ider(20q) and del(20q).
Typical morphological features in patients with ider(20q) (peripheral blood).
Typical morphological features in patients with ider(20q) (peripheral blood).
No relevant conflicts of interest to declare.
Author notes
Asterisk with author names denotes non-ASH members.

This feature is available to Subscribers Only
Sign In or Create an Account Close Modal